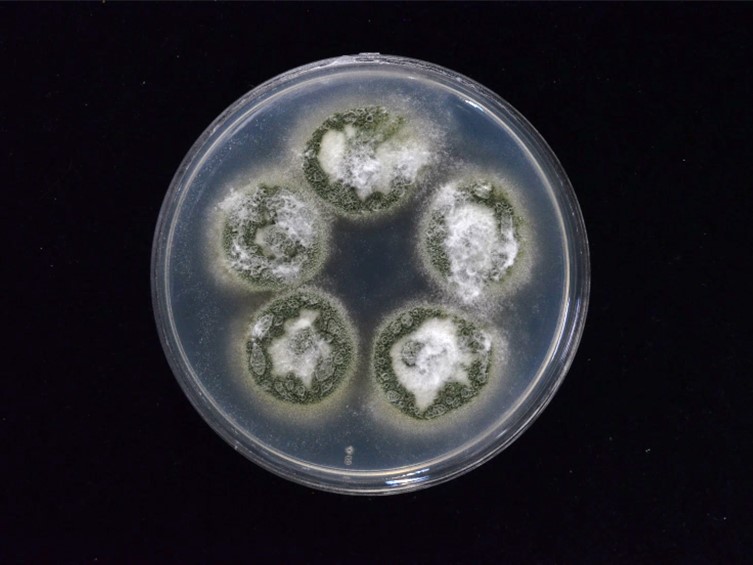

Holotype:
THAILAND, Nakhon Phanom Province, Ban Don Sala, 15 Jun. 2011, S. Mongkolsamrit, K. Tasanathai, P. Srikitikulchai, A. Khonsanit, K. Sansatchanon, W. Noisripoom, holotype BBH 30616, ex-type living culture BCC 48881.
Habitat:
In leaf litter.
Host:
Adult cicada (Hemiptera).
Description:
 Host covered by mycelium, pale green to greyish green, with heavy sporulation. Synnemata absent, mononematous. Conidia smooth-walled, dimorphic;
Host covered by mycelium, pale green to greyish green, with heavy sporulation. Synnemata absent, mononematous. Conidia smooth-walled, dimorphic;  microconidia ovoid, ellipsoidal, 3-6 × 2-4 μm;
microconidia ovoid, ellipsoidal, 3-6 × 2-4 μm;  macroconidia cylindrical, 12-22 × 3-4 μm.
macroconidia cylindrical, 12-22 × 3-4 μm.
Culture characteristics:
Colonies on PDA attaining a diam of 15 mm in 14 d, floccose, cream to green with age. Sporulation starts at 7 d after inoculation, reverse uncoloured. Conidiophores arising from hyphae, smooth-walled. Phialides solitary or in a group of three to ten borne directly on metulae, nomuraea-like, smooth-walled, cylindrical, 4.5–10 × 2–3 μm. Conidia smooth-walled, dimorphic; microconidia formed first, ovoid, ellipsoidal, 4–7 × 2–3.5 μm; macroconidia formed later, cylindrical, 10–24 × 3–4 μm.
Colonies on PDA attaining a diam of 15 mm in 14 d, floccose, cream to green with age. Sporulation starts at 7 d after inoculation, reverse uncoloured. Conidiophores arising from hyphae, smooth-walled. Phialides solitary or in a group of three to ten borne directly on metulae, nomuraea-like, smooth-walled, cylindrical, 4.5–10 × 2–3 μm. Conidia smooth-walled, dimorphic; microconidia formed first, ovoid, ellipsoidal, 4–7 × 2–3.5 μm; macroconidia formed later, cylindrical, 10–24 × 3–4 μm.
Reference:
Mongkolsamrit S, Khonsanit A, Thanakitpipattana D, et al. (2020). Revisiting Metarhizium and the description of new species from Thailand. Studies in Mycology 95: 171–251.
DOI: https://doi.org/10.1016/j.simyco.2020.04.001Species |
Strain |
Compound |
Pubchem CID |
Biological activity |
Reference |
|---|
|
Strain |
ITS | LSU | RPB1 | RPB2 | SSU | TEF1 |
|---|---|---|---|---|---|---|
| BCC 48696 | MT078881 | MN781848 | MN781752 | MN781800 | MN781948 | MN781703 |
| BCC 48881 | MN781885 | MN781849 | - | - | MN781949 | MN781704 |